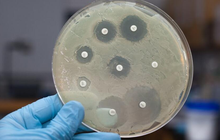

Đối phó mối đe dọa toàn cầu mang tên "kháng kháng sinh": Giải pháp từ các nhà khoa học đình đám tại VinFuture
Năm 2019, có 4,95 triệu người chết liên quan đến kháng kháng sinh và 1,26 triệu ca tử vong trực tiếp từ kháng kháng sinh. Đây được coi là một trong những mối đe dọa sức khỏe toàn cầu lớn nhất hiện nay.
- 3 loại gia vị dễ gây ung thư nhất? Bác sĩ nói thích đến mấy cũng dùng tiết kiệm khi nấu ăn
- Nhiều người đang già đi nhanh hơn vì ô nhiễm không khí, hóa ra sương mù trắng đục không chỉ gây khó thở
- "Thủy quái" của biển khơi, nhìn qua đã thấy rùng mình nhưng thịt ngon khó cưỡng lại bổ như sâm, là "món hiếm" trong giới ẩm thực
Kháng sinh penicillin được phát hiện một cách tình cờ vào năm 1928, mở ra kỷ nguyên cứu sống hàng triệu người, nó tác động lên vi khuẩn theo nhiều cơ chế khác nhau như ức chế tổng hợp protein… Tuy nhiên, càng ngày vi khuẩn càng thông minh hơn và kháng kháng sinh, tác động đích của kháng sinh và ngăn chặn, thay đổi tính thấm màng tế bào. Các cơ chế kháng thuốc xuất hiện ngay sau khi thuốc được đưa vào sử dụng rộng rãi. Và phải đến năm 1945, người ta mới bắt đầu có nhận thức về kháng kháng sinh peneceline.
Kháng kháng sinh được coi là một trong những mối đe dọa sức khỏe toàn cầu lớn nhất hiện nay. Theo thống kê, năm 2019, trên thế giới có khoảng 4,95 triệu người chết liên quan đến kháng kháng sinh, trong đó 1,26 triệu ca tử vong trực tiếp từ tình trạng kháng kháng sinh.
Nếu không có biện pháp can thiệp, ước tính đến năm 2050, siêu vi khuẩn kháng thuốc có thể gây ra hàng triệu ca tử vong mỗi năm, vượt qua cả bệnh ung thư.
Vệ sinh, vacxin, kháng sinh mới… là những chiến lược.
Kết hợp AI trong sản xuất kháng sinh
Tại tọa đàm “AI vì nhân loại: Đạo đức và An toàn AI trong kỷ nguyên mới” thuộc Tuần lễ Khoa học - Công nghệ VinFuture 2025 diễn ra chiều 2/12, PGS. César de la Fuente (Pháp) chỉ ra hướng giải pháp "Thúc đẩy nghiên cứu kháng sinh kết hợp AI".

PGS. César de la Fuente
Cụ thể, thuật toán máy tính có khả năng khai thác dữ liệu gen và protein để khám phá các hợp chất mới, ví dụ như các phân tử có tác dụng tăng cường miễn dịch hoặc tiêu diệt khối u. Mô hình học máy có thể tìm kiếm phân tử có tính kháng vi khuẩn, có kháng sinh tiềm năng của người cổ... Hay việc tìm kiếm các phân tử kháng sinh mới từ các sinh vật đã tuyệt chủng như voi cổ đại, mộc lan tiệt chủng, hay các mẫu vật cổ đại khác là một hướng đi tiềm năng để giải quyết vấn đề kháng kháng sinh.
PGS. César de la Fuente nhận định phát hiện ra kháng sinh mới nhờ AI rất tốc độ, giảm chi phí, tận dụng được nhiều nguồn lực, giúp đưa yếu tố từ phòng thí nghiệm ra đời thực.
Liệu pháp khuẩn thể - 1 giải pháp tiềm năng?
Một giải pháp khác là liệu pháp khuẩn thể, được GS. Pascale Cossart (Pháp) giới thiệu tại tọa đàm "Bước tiến trong phát hiện, chẩn đoán và điều trị bệnh" diễn ra vào sáng 3/12 cũng trong khuôn khổ Tuần lễ Khoa học - Công nghệ VinFuture 2025.

GS. Pascale Cossart
Theo đó, thực khuẩn thể đã được nhà vi sinh học người Pháp Felix d’Herelle phát hiện từ đầu thế kỷ trước và đặt tên liệu pháp này rồi phát triển trên toàn thế giới. Dù thành công vào năm 1919 nhưng tới 1930 sự phát triển của liệu pháp này bắt đầu chậm lại và dừng. Dù vậy, ở thời điểm đó, nó đã điều trị cho một trẻ 12 tuổi có kết quả tốt.
Hiện nay vấn đề kháng kháng sinh tăng lên khiến cho liệu pháp thực khuẩn thể được chúng ta nhìn nhận trên góc độ mới và ngày càng được nhiều quốc gia lựa chọn sử dụng. Chẳng hạn như Georgia (cụ thể là tại Viện Eliava nổi tiếng) đã sử dụng liệu pháp thực khuẩn thể trong gần 100 năm qua. Hay Ba Lan cũng là một quốc gia sử dụng rộng rãi liệu pháp này. Pháp và các quốc gia Châu Âu khác đang tổ chức để triển khai liệu pháp này. Hoa Kỳ có 4 trung tâm đang áp dụng rộng rãi.
Đặc hiệu của liệu pháp thực khuẩn thể là nó có tính đặc hiệu cao đối với từng loài vi khuẩn cụ thể. Chúng tự nhân lên (tăng số lượng) ngay tại vị trí nhiễm trùng và tiêu diệt mục tiêu mà không làm hại đến các vi khuẩn có lợi trong cơ thể. Yêu cầu làm sạch thực khuẩn thể cũng rất khắt khe. Cần loại bỏ hoàn toàn nội độc tố vi khuẩn (LPS - Lipopolysaccharide) để tránh gây ra phản ứng viêm nhiễm nguy hiểm.
Thực khuẩn thể được coi là một giải pháp trong cuộc chiến chống lại kháng kháng sinh. Với những tiến bộ trong công nghệ sinh học (giống như cách liệu pháp tế bào CAR-T được tùy chỉnh cho ung thư), liệu pháp thực khuẩn thể đang có nhiều hứa hẹn sẽ được áp dụng rộng rãi hơn trong tương lai gần.